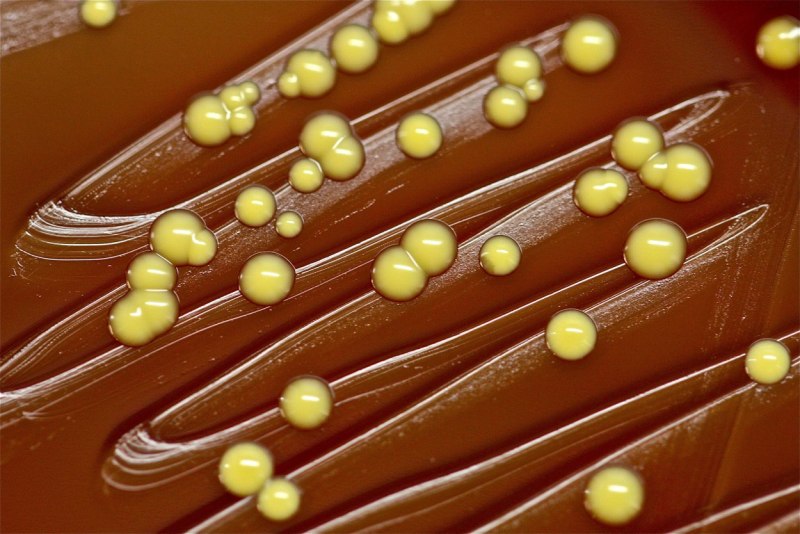

Бактерии микрококки (69 фото)
Комментарии (0)

Грамположительные кокки. Микрококки.

Bacillus Cereus окраска по Граму

Форма бактерий кокки палочки извитые

Микрококки Лютеус

Кокки сарцина

Micrococcus glutamicus

Кокки бактерии

Micrococcus luteus под микроскопом

Микрококки шаровидные микроорганизмы

Кокки бактерии фото

Микрококки заболевания


Микроскопия мазка сарцины

Микрококки Лютеус на чашке Петри

Грамположительные кокки и грамотрицательные палочки

Диплококки бактерии

Ld50 bacteria Toxin

Стафилококк эпидермидис

Микрококки стрептококки стафилококки

Микрококки Лютеус

Кокки микробиология

Стрептококки форма бактерии

Морфология колоний микроорганизмов

Микрококкус розеус

Стафилококкус ауреус

Грамположительные кокки. Стафилококки.

Круглые бактерии

Микрококки диплококки тетракокки сарцины стрептококки стафилококки

Грамотрицательные микрококки

Micrococcus luteus микроскоп

Micrococcus luteus колонии

Пневмококк diplococcus

Золотистый стафилококк MRSA

Бактерии стафилококки

Микрококки диплококки

Микрококки диплококки стрептококки стрептококки стафилококки

Бактерии в форме палочки

Стафилококки Equi

S. aureus золотистый стафилококк

МРЗС бактерия

Стрептококки бациллы спириллы вибрионы

Staphylococcus aureus микроскопия

Стафилококк окраска по Граму

Микрококкус розеус

Шаровидные бактерии кокки рисунок

Бактерия Micrococcus luteus

Микрококки Лютеус
Микрококки Лютеус

Стафилококк aureus

Шаровидные бактерии кокки


Стафилококки генцианвиолет

Стафилококк строение

Micrococcus luteus под микроскопом

Кокки стафилококки

Micrococcus luteus микробиология

Метициллинрезистентный стафилококк (MRSA

Микрококки Лютеус

Микрококки Лютеус

Стафилококк ауреус под микроскопом

Micrococcus Agilis в микроскопе

Шаровидные бактерии кокки

Стафилококк сапрофитикус

Micrococcus luteus на питательной среде

Micrococcus luteus микроскоп

Пневмококк золотистый стафилококк

Стафилококк ауреус Петри

Грамположительные кокки. Микрококки.

Микрококки Лютеус
Читайте также

---
Бактерии сенная палочка (72 фото)

---
Бактерии золотистый стафилококк (69 фото)

---
Бактерии метициллинрезистентный золотистый стафилококк (61 фото)

---
Бактерии пневмококк (66 фото)

---
Бактерии хроококковые (72 фото)

---
Бактерии планктомицеты (69 фото)

---
Круглые черви европы (70 фото)

---
Круглые черви азии (73 фото)

---
Бактерии гамма протеобактерии (69 фото)

---
Бактерии спироплазма (67 фото)

---
Бактерии ацетобактер (67 фото)

---
Бактерии фирмикуты (71 фото)